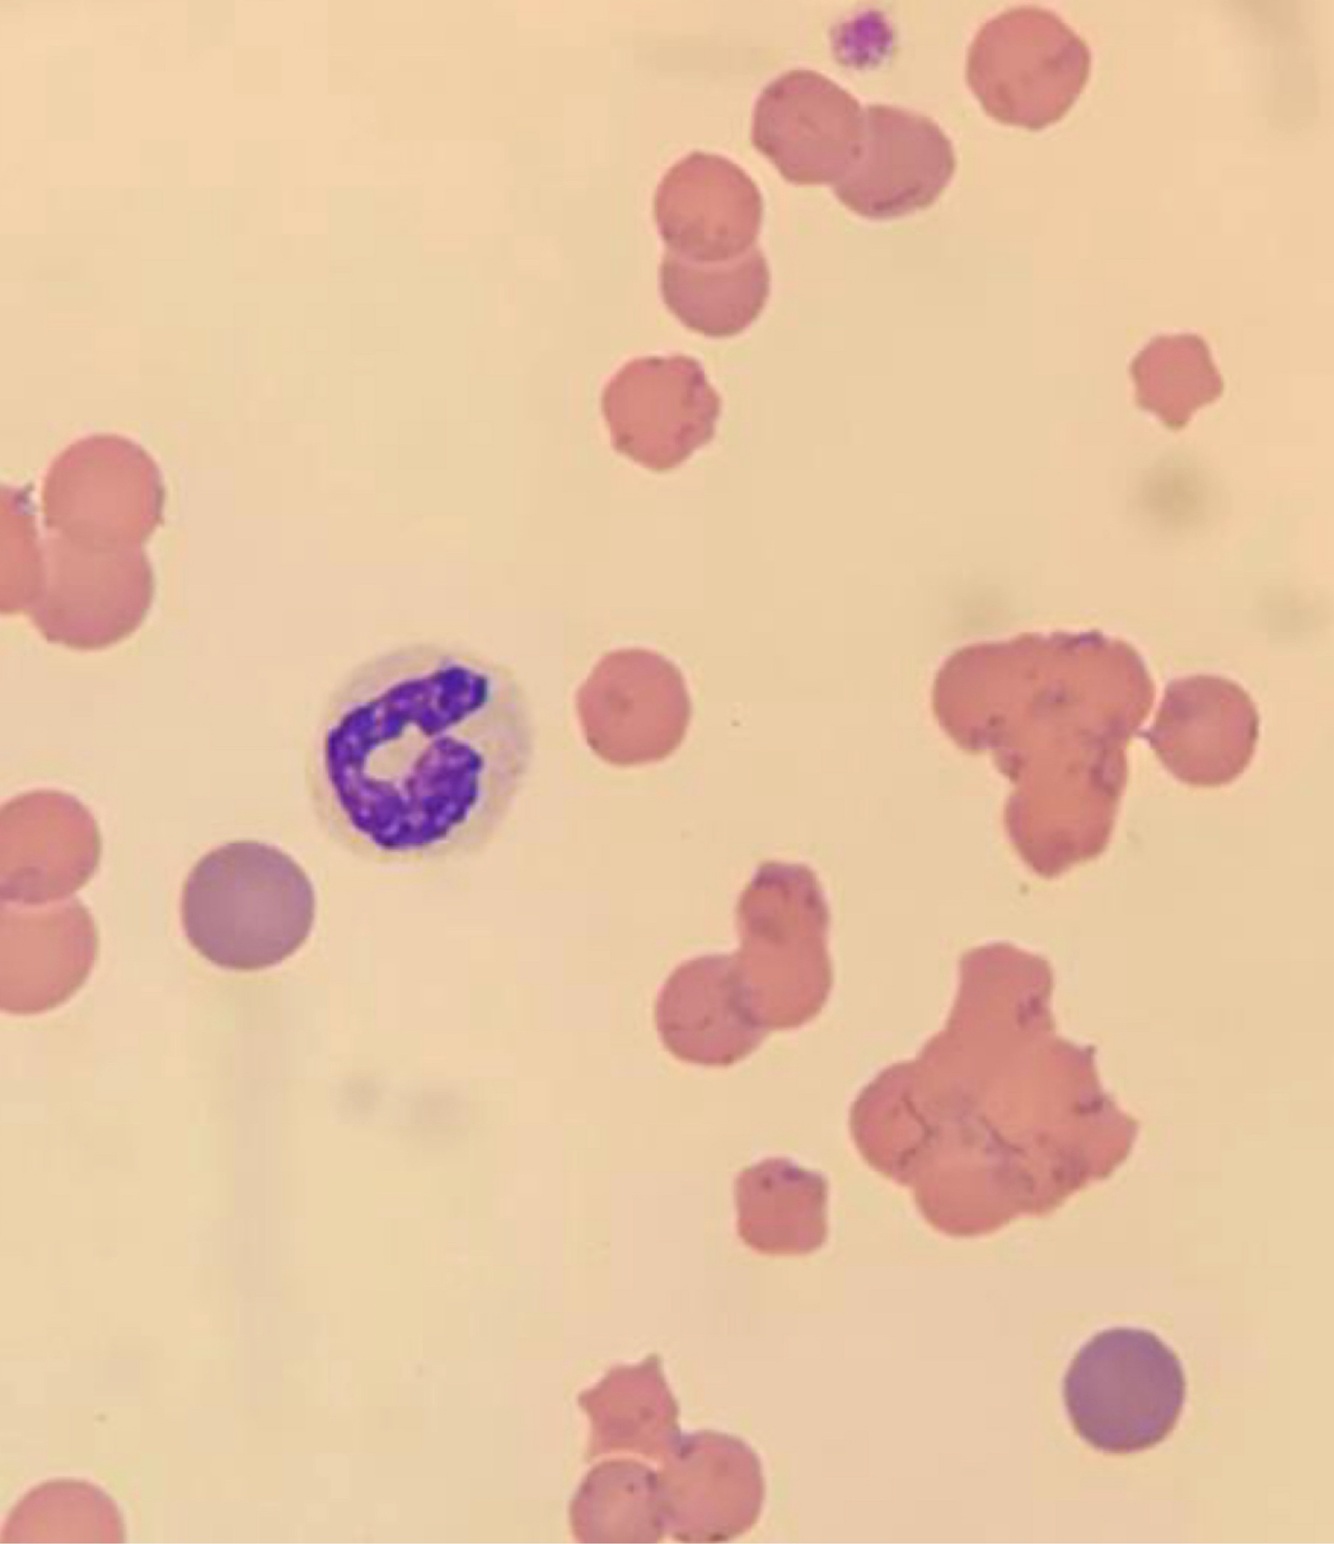
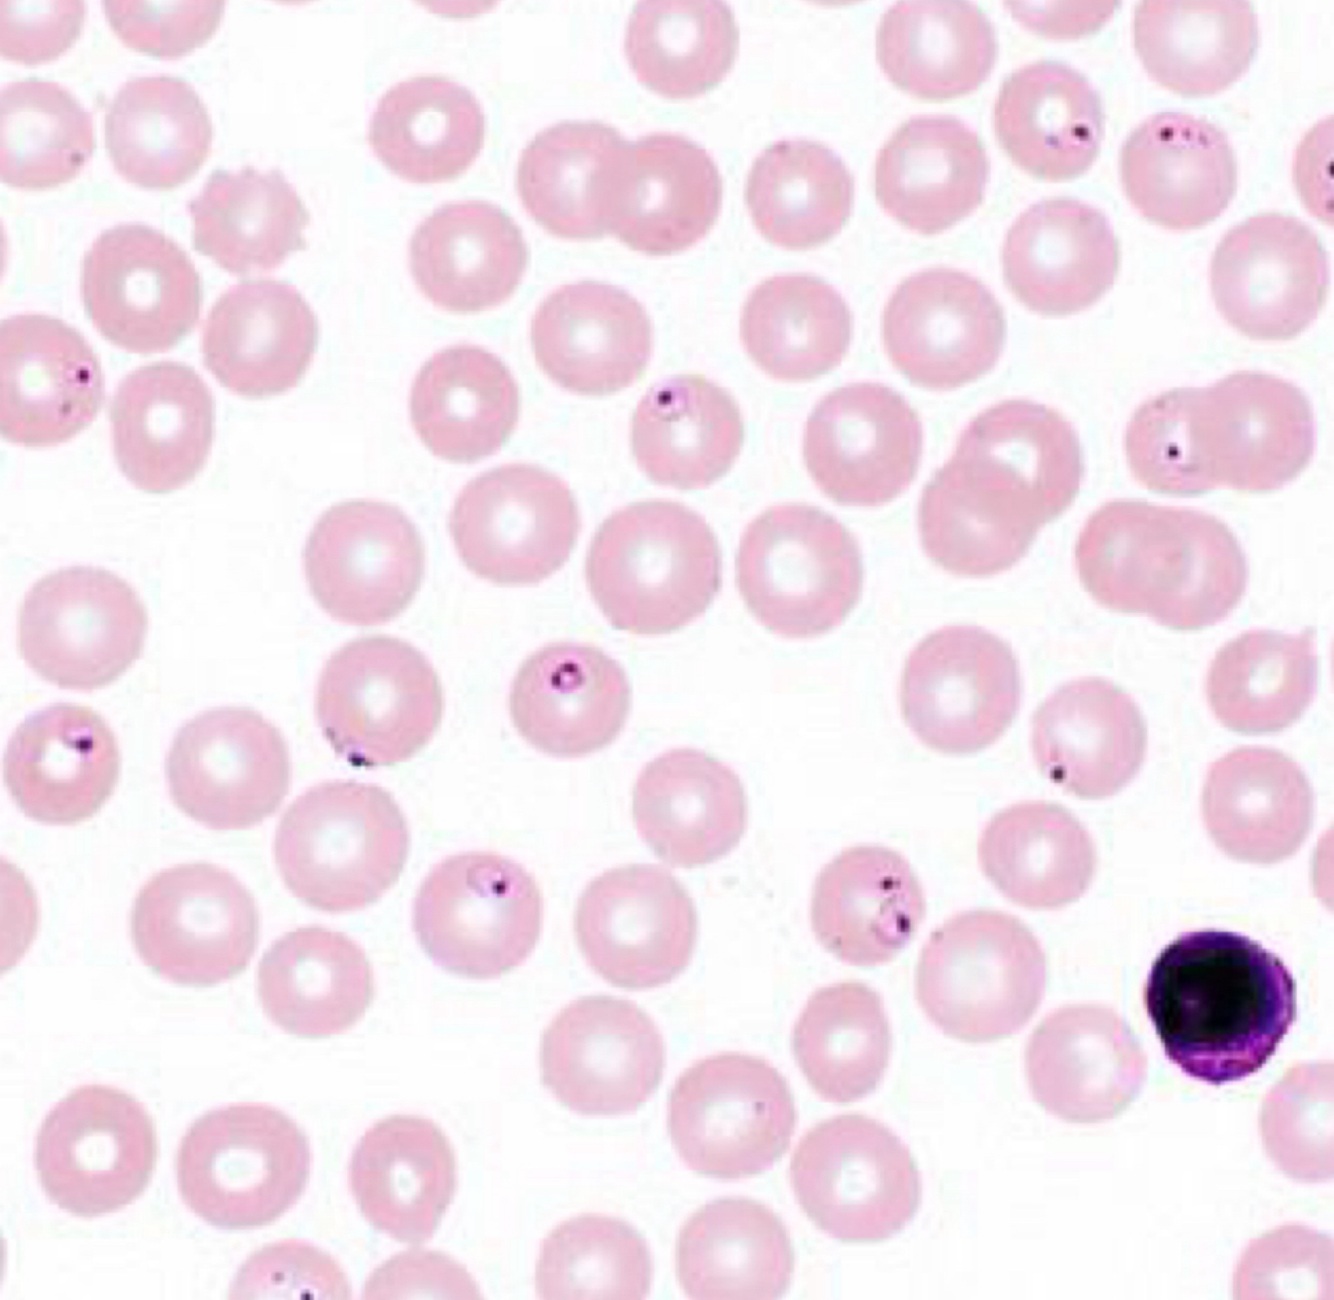
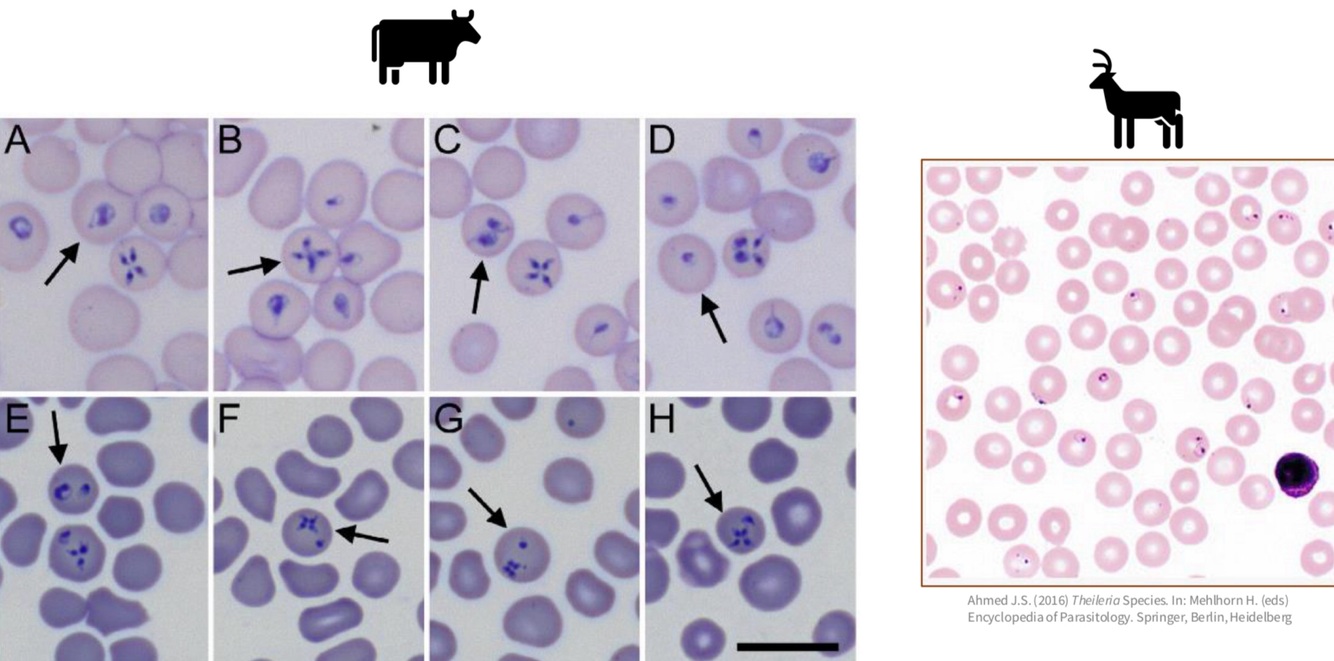
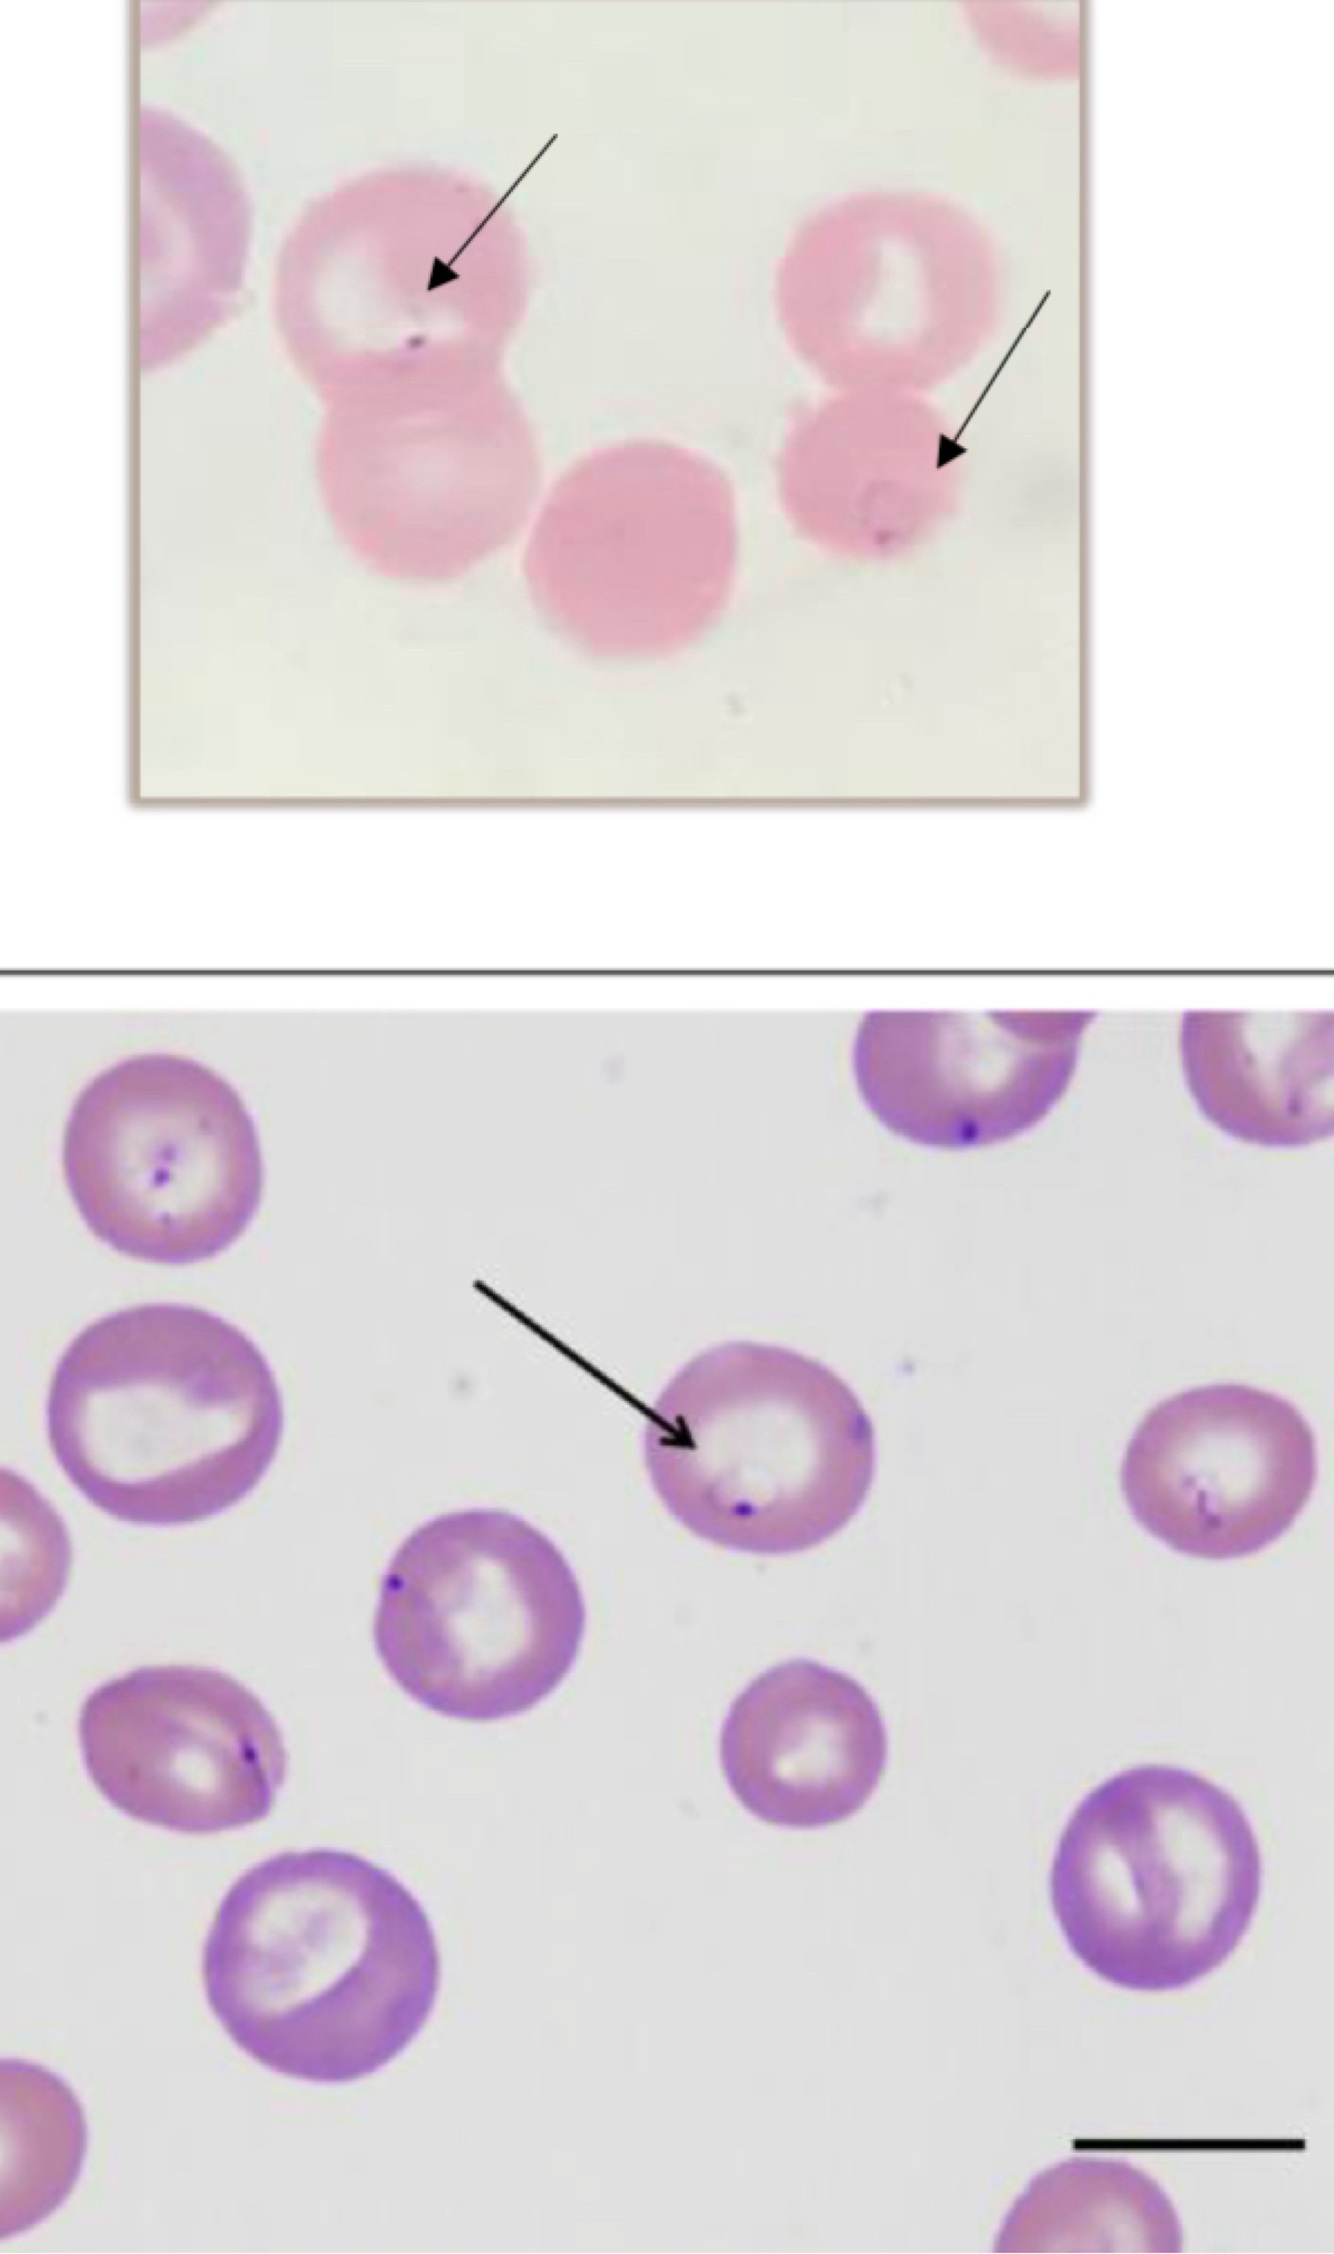
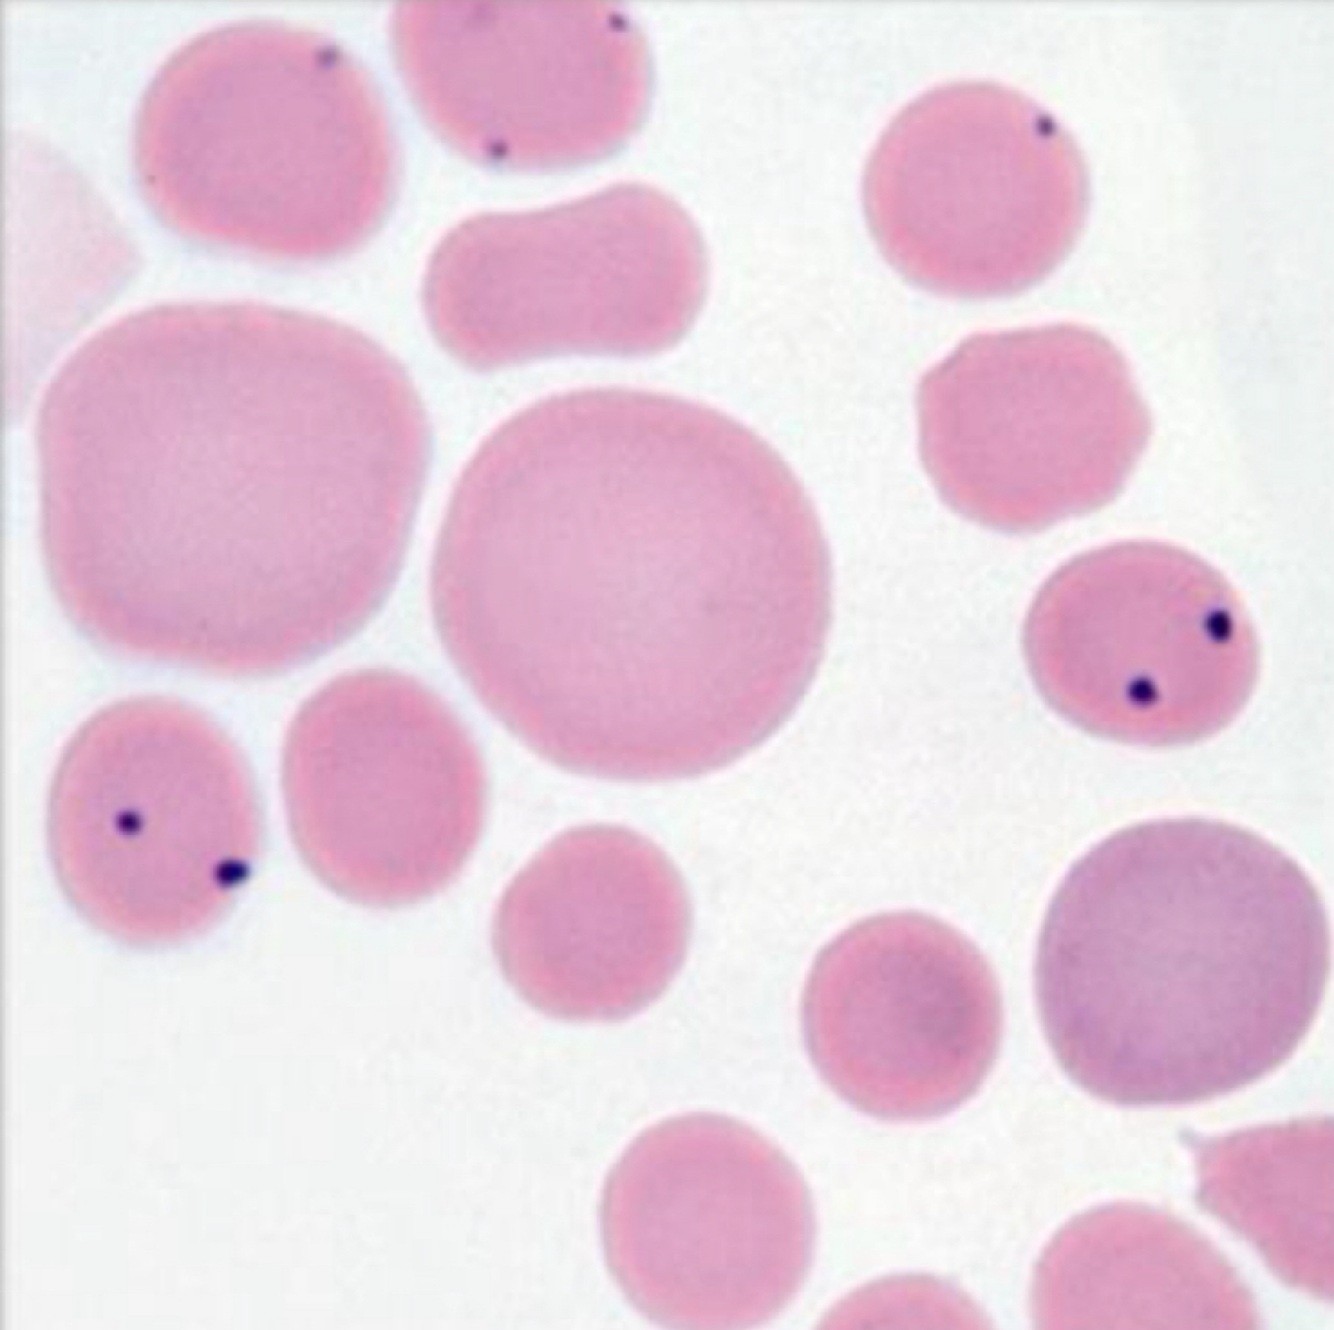

Hemotropic Mycoplasmas
gram-negative bacteria

- epicecullar parasites - associated w/ membrane surface
- very small cocci, rod, or ring-shaped structures
- found individually or in chains
- PCR testing rec. for definitive diagnosis if infxn suspected
- most domestics have at least 1 species that infects them
- when they cause anemia 🡒 expect hemolytic anemia (often extravascular)
- treated animals may become carriers 🡒 recurrence possible

- can fall of RBCs during transport in vitro
- can be confused for stain precipate or vice versa
Mycoplasma haemofelis
formerly hemobartonella felis

- can cause disease in normal animals
- concurrect retroviral infection (FeLV/FIV) can 🡑 susceptibility
- infxn can result in severe hemolytic anemia
- cyclic parasitemia
- survivors often remain carriers
Transmission:
- presumptive vectors: fleas, ticks, mosquitoes
- blood (+ transfusions)
- vertical (queen 🡒 kittens)
Theileriosis
protozoan
protozoal organism that affects ruminants + cervids
species in US are often non-pathogenic but can cause hemolytic anemia
multi-stage lifecycle
- piroplasms in RBCs
- schizonts in lymphocytes
Morphologic overlap between several IC organisms:
Theileria spp. + cytauxzoon felis + babesia spp.
we use patient species +/- geographic location to develop plausible differential diagnosis lists
then use molecular testing to definitively identify organism
Cytauxzoon felis
(protozoan)

feline pathogen of southern + south-central + midwest + mid-atlantic US
piroplasms in RBCs
- basophillic, round to signet-ring structures
- ~1-3 microns in diameter
bobcat (lynx rufus) is the wild reservoir
tick vectors
schizonts in tissue macrophages
- these parasitized macrophages are very large + affect blood flow + cell function in affected organs 🡒 accumulation is main cause of clinical signs
can cause severe disease + fatality
- marked depression + lethargy
- high fever
- marked icterus
- leukopenia + thrombocytopenia
- anemia
often fatal for cats that become symptomatic
Babesiosis
protozoan
mainly seen in dogs + cattle
sporozoites penetrate + multiply in RBCs
- can rupture RBCs + subsequently invade other RBCs
- cause IV hemolytic anemia +/- thrombocytopenia
- do not infect other cell types
large (>3u) + small (<3u) Babesia spp.

Anaplasmosis
rickettsia
Cattle - anasplasma marginale
- tick vectors, mechanical transmission
- 🡑 parasitemia occurs until anemia develops 🡒 hemolytic crisis
- fever, mild to severe anemia
- survivors become chronic carriers + serve as reservoirs
Must be differentiated from howell-jolly bodies:
- usually anaplasma organisms are not perfectly round + may be smaller than typical H-J bodies
Hemoproteus + Hemogregarines
protozoa

Birds = hemoproteus v reptiles = hemogregarines
usually non to mild pathogenic
Plasmodium
protozoa

birds + reptiles
clinical dz more common to certain bird species
Leukocytozoon
protozoa

birds
pathogenicity low for most birds
Microfilaria

dirofilaria immitis = dogs + cats
dirofilaria repens = dogs + cats in europe
anathoceilonema reconditum = dogs
setaria sp. = cattle + horses
- intestinal roundworm that has a microfilarial stage


